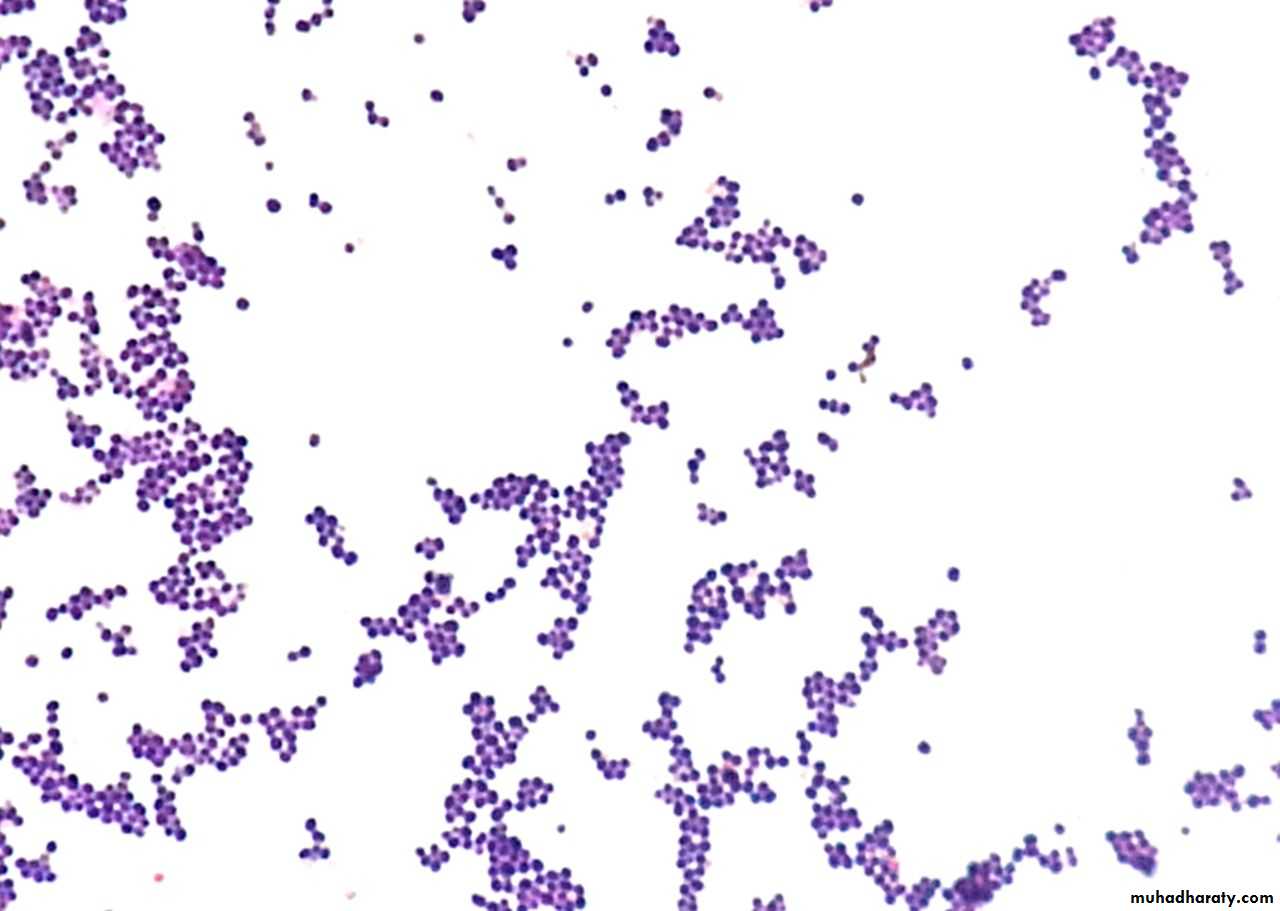

Ninevah University
College of MedicinDepartment of medical microbiology
Introduction to the Medical Microbiology
Microbiology: The science that deals with the study of microorganisms
Medical microbiology: is the study of causative agents of infectious disease of humans and it deals with etiology, Pathogenesis, laboratory diagnosis, specific treatment and control of infection.Bacteriology: the science of Bacteria, that causative agents of a member of infectious diseases.
Virology: the science of virus, noncellular living systems, capable of cause infectious disease in human.
Mycology: the study of fungi and yeast pathogenic for human.
Parasitology: the science that study of parasites (protozoans and helminths) and parasitism.
Immunology: the branch of biomedical science, concerned with the response of organism to antigenic challenge, the recognition of self and not self and all the biological (invivo) serological (invitro).
• It encompasses the study of the structure and function of the immune system,
• Immunization (vaccination)• Organ transplantation
• Blood banking
• Blood banking
Pathogenicity: The ability to cause disease in the host.
Virulence: The ability to cause severe disease in the host.Immunogenicity: The ability to induce an immune response in the host.
Infectious dose: Number of organisms needed to successfully infect.
Latent period: Exposure to infectiousness interval.
Incubation period: Interval from exposure to clinical symptoms.
Infectious period: Interval during which host can transmit infection.
Endemic: Present or usually prevalent in a population or geographical area at all times.
Epidemic: Occurring suddenly in numbers clearly in excess of normal expectancy.
Pandemic: Wide spread epidemic of disease, distributed or occurring widely throught out a region country, or continent or globally.
The History Microbiology
Microbes were first observed by Antonie van Leeuwenhoek using a simple microscope (ca. 1673)
So the Leeuwenhoek is associated with microscope.
Louis Pasteur: is also known as father of medical microbiology.
He has many contributions to microbiology:1. He has proposed the principles of fermentation for preservation of food.
2. He described the method of pasteurization of milk
3. He introduced sterilization techniques and developed steam sterilizer, hot air oven and autoclave.
4. He had also contributed for designing the vaccines against several diseases such as Anthrax, Fowl cholera and Rabies.
5. He disproved the theory of spontaneous generation of disease and postulated the ‘Germ theory of disease’. He stated that disease cannot be caused by bad air or vapor, but it is produced by the microorganisms present in air.
6. Liquid media concept- He used nutrient broth to grow microorganisms.
7. He was the founder of the Pasteur Institute, Paris.
Robert Koch: Robert Koch provided remarkable contributions to the field of microbiology
1. He used of solid media for culture of bacteria.2. He also introduced methods for isolation of bacteria in pure culture.
3. Described hanging drop method for testing motility.
4. Discovered bacteria such as the anthrax bacilli, tubercle bacilli and cholera bacilli.
5. Introduced staining techniques by using dye.
6. Koch’s phenomenon: Robert Koch observed that guinea pigs already infected with
tubercle bacillus developed a hypersensitivity reaction when injected with tubercle
bacilli or its protein. This reaction is called Koch’s phenomenon.
7. Koch’s Postulates
Koch’s Postulates
1- Pathogen must be present in all cases of disease.2- Pathogen must be isolated and grown in lab in pure culture.
3- Pathogen from pure cultures must cause disease when inoculated into healthy, susceptible lab animal.4- Same pathogen must be isolated from the diseased lab animal.
1. Belong to the Protista biologic kingdom.2. Include some eukaryotes and prokaryotes, viruses, viroids, and prions.
3. Are classified according to their structure, chemical composition, and biosynthetic and genetic organization.
Two fundamentally different types of cells are classified in the microbial world, Prokaryotic .. Eukaryotic cells.
Eukaryotic cells have a "true" nucleus.. Prokaryotic cells have a naked nucleus/ composed of a single DNA Chromosome.. not enclosed within a nuclear membrane.
Bacterial, Fungi, Parasites cells are of fundamental importance in the classification, identification & pathogenicity of these microbes in Laboratory.
(Eukaryotr) Example: All Bacteria (Mycoplasma, Rickettsia, Shigella, Chlamydia).
(Prokaryote) Example: Fungus, Entamoeba, Helminths, Parasites, Protozoa.
Classification of Microorganisms
Comparison of Prokaryotic and Eukaryotic Cell Organization
CharacteristicProkaryote
Eukaryote
Typical size
0.4-2 μm in diameter
10-100 μm in diameter
Nucleus
No nuclear membrane; nucleoid region of them cytosol
Classic membrane-bound nucleus
Chromosomal DNA
Circular; complexed with RNA
Linear; complexed with basic histones and other proteins
extrachromosomal
circular DNA
Plasmids, most commonly found in gram-negative bacteria; each carries genes for its own replication; can
confer resistance to antibiotics
In mitochondria and chloroplasts
Reproduction
Asexual (binary fission)
Sexual and asexual
Membrane-bound organelles
Absent
All
Golgi bodies
Absent in all
Present in some
Lysosomes
Absent in all
Present in some
Endoplasmic reticulum
Absent in all
Present in all; lipid synthesis, transport
Mitochondria
Absent in all
Present in most
Nucleus
Absent in all
Present in all
Ribosomes Size
70S in size, consisting of 50S and 30S subunits
80 S in size, consisting of 60 S and 40 S subunits
Sterols in cytoplasmic membrane
Absent except in Mycoplasma spp.
Present
Plasma membrane
Lacks carbohydrates
Also contains glycolipids and glycoproteins
Cell wall, if present
Peptidoglycan in most bacteria
chitin (fungi), other glycans (algae)
Cilia
Absent
Present
Pili and fimbriae
Present
Absent
Flagella, if present
Simple flagella
Complex flagella
Linnaeus: introduced the binomial system of scientific nomenclature.
• Each organism has two names: the genus and species epithet
• Italicized or underline
• Genus name the first letter writes capital letter, while the species name is writes small letter.
Example Scientific Names
Staphylococcus aureus or Staphylococcus aureus
Escherichia coli or Escherichia coli
Nomenclature the bacteria
Learning Objectives
Answer questions about bacterial structure, and bacterial growth and classification.Both Gram-positive and Gram-negative cell envelopes have the following
properties:The Bacteria
Bacterial StructureBacterial Structure
Bacterial StructureA. Shape: Along with other properties, shape is used to identify bacteria.
1- Appropriate staining and a light microscope.2- Types,
a. Round (coccus) Streptococcus pneumoniae and Staphylococcus aureus
b. Rod-like (bacillus) Bacillus anthracis and Clostridium tetani
c. Spiral Treponema pallidum and Leptospira interrogans,
Bacterial Structure
3. Cocci and bacilli often grow in doublets (diplococci) or chains (streptococci). Cocci that grow in clusters are called staphylococci.4. Some bacterial species are pleomorphic, such as Bacteroides.
5. Antibiotics that affect cell wall biosynthesis (e.g., penicillin) may alter a bacteria’s shape.
B. Nucleus: In bacteria, the nucleus generally is called a nucleoid or nuclear body
The bacterial nucleus is not surrounded by a nuclear membrane,C. Cytoplasm:
1. Bacterial cytoplasm contains ribosomes and various types of nutritional storage granules.2. It not contains organelles
D. Cytoplasmic Membrane:
1. Structure. The cell membrane is a typical phospholipid bilayer that contains the following constituents:a. Cytochromes and enzymes involved in electron transport and oxidative phosphorylation.
b. Carrier lipids, enzymes, and penicillin-binding proteins (PBP) involved in cell Wall biosynthesis.
c. Enzymes involved in phospholipid synthesis and DNA replication.
d. Chemoreceptors.
2. Functions:
a. Selective permeability and active transport facilitated by membrane-bound permeases, binding proteins, and various transport systems.
b. Site of action of certain antibiotics such as polymyxin.
E. Plasmids:
1. Structure. Plasmids are small, circular, non-chromosomal, double stranded DNA molecules that are:a. Capable of self-replication.
b. Most frequently extrachromosomal
c. But may become integrated into bacterial DNA.
2. Function: contain genes that confer protective properties
• Resistance to Antibiotics• Bacteriocins production
• Enterotoxin production
• Enhanced pathogenicity
• Reduced Sensitivity to mutagens.
F. Transposons:
G. Cell envelope:
1. Structure. The cell envelope is composed of the macromolecular layers that surround the bacterium. It includes:a. A cell membrane and a peptidoglycan layer except for mycoplasma.
b. An outer membrane layer in Gram-negative bacteria.
c. A capsule, a glycocalyx layer, or both (sometimes).
d. Antigens that frequently induce a specific antibody response.
2. Cell wall:
a. The cell wall refers to that portion of the cell envelope that is external to the cytoplasmic membrane and internal to the capsule or glycocalyx.
b. It confers osmotic protection and Gram-staining characteristics.
c. In Gram-positive bacteria it is composed of:
• Peptidoglycan
• Teichoic and teichuronic acids
• Polysaccharides
d. In Gram-negative bacteria, it is composed of:
• Peptidoglycan• Lipoprotein
• Lipopolysaccharide
• Porin channels
3. Peptidoglycan (also called mucopeptide or murein) is unique to prokaryotes. It is found in all bacterial cell walls except Mycoplasma contian Sterol.
• Peptidoglycan is the site of action of certain antibiotics such as penicillin and the cephalosporins.
• In Gram-positive bacteria, it comprises up to 50% of the cell wall. In Gram-negative bacteria, it comprises only 2% to 10% of the cell wall.
4. Lipoprotein is found in Gram-negative bacteria.
5. The periplasmic space is found in Gram-negative cells.
• a. It refers to the area between the cell membrane and the outer membrane.• b. Hydrated peptidoglycan, as well as hydrolytic enzymes including a-lactamases, specific carrier molecules, and oligosaccharides are found in the periplasmic space.
6. An outer membrane is found in Gram-negative cells.
including matrix porins (nonspecific pores).
Functions:
• Protects cells from harmful enzymes and some antibiotics.• Prevents leakage of periplasmic proteins.
7. Lipopolysaccharide (LPS) is found in the outer leaflet of the outer membrane of Gram-negative
cells.
Functions:
• Also called endotoxin; the toxicity is associated with the lipid A.
• Contains major surface antigenic determinants, including O antigen found in the polysaccharide component.H. External layers:
1. Surface proteins:a. These antiphagocytic proteins are external to the cell wall of some Gram-positive bacteria.
b. Functions: act as adhesins facilitating tissue colonization with several species (e.g., Staphylococcus aureus [fibronectin-binding proteins] and Streptococcus pyogenes [F proteins]).
2. Capsule:
a. The capsule is a well-defined structure of polysaccharide surrounding a bacterial cell and is external to the cell wall. The one exception to the polysaccharide structure is the poly-D-glutamic acid capsule of Bacillus anthracis.b. Functions: protects the bacteria from phagocytosis and plays a role in bacterial adherence.
So the role of the Bacteria capsule Antiphagocytic.
Example:
Capsulated Organism:
(Klebsiella pneumonia, Streptococcus pneumonia)
J. Appendages:
1. Flagella are protein appendages for locomotion and contain prominent antigenicdeterminants. Composed of subunits of a single protein (flagellin). Play a role in pathogenesis of UTI by propelling the bacteria up the urethra into the bladder. Non motile like Shigella (because it does not have flagella.
(A) monotrichous;
(B) lophotrichous;
(C) amphitrichous;
(D) peritrichous.2. Pili (fimbriae)
• Hair like filaments of protein.• Extend from the bacterial surface.
• Found mainly on gram-negative organisms.
• Mediate attachment of bacteria to the surface of human cells.
• Mutants of Neisseria gonorrhoeae that do not form pili are nonpathogens.
• Fimbriae are important virulence factors as an adhesin in Escherichia coli (urinary tract), Neisseria gonorrhoeae.
• F pili (Sex)
• Promote transfer of large segments of bacterial chromosome
between bacteria.
• Encoded by a F plasmid.
K. Endospores:
1. Are formed as a survival response to certain adverse nutritional conditions, such as depletion of a certain resource. These metabolically inactivebacterial cells are highly resistant to desiccation, heat, and various chemicals.
They are helpful in identifying some species of bacteria (e.g., Bacillus and Clostridium).
Function: endospores germinate under favorable nutritional conditions after an activation process that involves damage to the spore coat. They are not reproductive structures.
K. Endospores:
Example of spores:
• Endospore: Bacillus subtilis• Terminal: Clostridium tetani
• Subterminal: Clostridium botulinum
Bacterial Structure Notes
Mycobacterium Spp.Peptidoglycan (slightly different)
Wax like lipid coat of mycolic acid
More than 60% of the cell wall is lipid, and the major lipid component is mycolic acid,
Cord factor
Wax D
Sulfolipids
Acid-fast staining
The coat responsible for virulence and antiphagocytic.
Corynebacterium & Nocardia
Produce mycolic acid lipids.
Mycoplasmas and Ureaplasma
No peptidoglycan absence of Cell Walland contain sterols in their cell membranes
Generation Time:
The time required for a bacterium to give rise to two daughter cells under optimum condition.Escherichia coli (20 minutes)
Mycobacterium tuberculosis (16 hours)
Mycobacterium leprae (13 days)
Bacterial Growth
Growth Curve1- Lag phase, during which bacteria are preparing to divide. Bacterial cell size increase.
2- Log phase or Exponential, during which bacteria numbers increase logarithmically, cells in this stage are generally more susceptible to antibiotics.
3- Stationary phase, cells exhaust essential nutrients or accumulate toxic products.
4- Death or decline phase, cells may die due to toxic products.
Factors Affecting Growth of Bacteria
1- Oxygen:a- Obligate aerobes (lack of oxygen kills the bacteria)
Mycobacterium tuberculosis and Nocardia asteroides
b- Obligate anaerobes (Oxygen kills the bacteria);
Clostridium tetani & Bacteroides
Bacterial Growth
Factors Affecting Growth of Bacteria
1- Oxygen:c- Facultative anaerobes
can shift their metabolism (anaerobic if oxygen is absent or aerobic
if oxygen is present); Escherichia coli and Staphylococcus
d-Microaerophilic
• grow well in low oxygen concentrations and highercarbon dioxide e.g. Campylobacter Spp. & Helicobacter pylori,
which requires 5% to 6% oxygen.
• Capnophilic bacteria require extra carbon dioxide (5% to 10%)
for growth; an example is H. influenzae
Bacterial Growth
Factors Affecting Growth of Bacteria
2- pH• Most pathogenic bacteria grow between pH 7.2 - pH 7.6.
• Very few bacteria (Lactobacilli) can grow at acidic pH below pH 4,
• Bacteria such as Vibrio cholerae are capable of growing at alkaline pH (8.2–8.9).
3- Temperature
• Psychrophiles• Mesophiles 20 °C - 45 °C Pathogenic Bacteria.
• Thermophiles
• Hyperthermophiles
Bacterial Growth
General characteristics:• Is the sum of anabolic processes (synthesis of cellular constituents requiring energy) and catabolic processes (breakdown of cellular constituents with concomitant release of waste products and energy-rich compounds).
• Pathogenic bacteria exhibit heterotrophic metabolism.
• Metabolism can vary depending on the nutritional environment.
• Bacterial transport systems involve membrane-associated binding or transport proteins for sugars and amino acids.
• Energy is frequently required to concentrate substrates inside the cell.
• Phosphotransferase systems are frequently used for sugar transport.
Bacterial Metabolism
Bacterial Metabolism
General characteristics:Essentıal Elements:
• Bacterial structure is made up of various components eg. carbohydrates, lipids, proteins, nucleic acids.
• These compounds are made up of four basic elements viz. C, H, O, and N.
• Besides these four elements, phosphorus and Sulphur are also required for bacterial growth.
Bacterial Metabolism
General characteristics:• After Sugars are made or obtained, they are the energy source of life.
• Breakdown of sugar(catabolism) different ways:Aerobic respiration
Anaerobic respiration
Fermentation
Bacterial Metabolism
• Carbohydrate metabolism
• Fermentation• Is a method of obtaining metabolic energy that is characterized by substrate phosphorylation.
• Adenosine triphosphate (ATP) formation is not coupled to electron transfer.
• An organic electron acceptor (e.g., pyruvate) is required.
• Specific metabolic end products are synthesized, which may aid in the identification of bacterial species.
• Respiration
• Refers to the method of obtaining metabolic energy that involves oxidative phosphorylation
• ATP is formed during electron transfer and the reduction of gaseous oxygen in aerobic respiration.
• cell membrane electron transport chain composed of cytochrome enzymes, lipid cofactors, and coupling factors is used during this process.
Bacterial Metabolism
The microbial pathogenicity depends upon several factors:-
1- Colonization:Adherence to cell surface
• pili / fimbriae: most gram negative bacteria.
• Teichoic acid: most gram positive bacteria.
• Adhesins: colonizing factor adhesins, pertussis toxin, hemagglutinins.
• Biofilms: Staphylococcus epidermidis, Pseudomonas aeruginosa.
• IgA proteases: make it easier to colonize pathogens.
2- Avoiding Destruction by Host Defense System
• Capsul exm. Streptococcus pnuemonia
• M protein Streptococcus pyogenes
• A protein Staphylococcus aureus
• IgA protease, destruction of muscosal IgA (Neisseria, Heamophilus, Streptococcus pneunomia)
Microbial Pathogenicity
The microbial pathogenicity depends upon several factors:-
3- Antigenic Variation
• Changing surface antigens to avoid immune destruction
• Neisseria gonorrhoeae------ pili & outer membrane proteins
• HIV & Influenza------- Antigenic drift.
4- Ability to Survive Intracellularly
• Evading intracellular killing by professional phagocytic cells allows intracellular growth:
• Mycobacterium tuberculosis survives by inhibiting phagosome-lysosome fusion.
• Listeria quickly escapes the phagosome into the cytoplasm before phagosome-lysosome fusion.
• Examples of Obligate intracellular Bacteria include:
• Mycobacterium leprae
• Rickettsia
• Chlamydia
• Coxiella
Microbial Pathogenicity
The microbial pathogenicity depends upon several factors:-
5- Physical Damage• Swelling from infection in a fixed space damages tissues; examples: meningitis and cysticercosis.
• Large physical size of organism may cause problems; example: Ascaris lumbricoides blocking bile duct.
• Immune-Mediated Damage
• Cross-reaction of bacteria-induced antibodies with tissue antigens causes disease. Rheumatic fever is one example.
• Immune complexes damage the kidney in post streptococcal acute glomerulonephritis.
Microbial Pathogenicity
The microbial pathogenicity depends upon several factors:-
6- Toxins:
Toxins may aid in invasiveness, damage cells, inhibit cellular processes, or trigger immune response and damage.
Types:
A- Endotoxin: (lipopolysaccharide = LPS)
• LPS is apart of gram negative outer membrane (virulence factor in Gram negative septic shock)
• LPS is heat stable and not strongly immunogenic, so cannot be converted to a toxoid.
• Cause fever, hypotension, disseminated intracellular coagulation, and shock.
B- Exotoxins are secreted by Gram-positive and Gram-negative bacteria; they may be genetically encoded in the bacterial chromosome, a plasmid, or a phage.
• A-B (or “two”) component protein toxins
• B component binds to specific cell receptors
• A component is the active (toxic) component
• Cytolysins: lyse cells from outside by damaging membrane.
• C. perfringens alpha toxin is a lecithinase.
• Staphylococcus aureus alpha toxin inserts itself to form pores in the
• membrane.
Microbial Pathogenicity
Differences between bacterial endotoxins and exotoxins
Microbial PathogenicityEndotoxins Exotoxins
Endotoxins Exotoxins
Lipopolysaccharides in nature Protein in nature
Lipopolysaccharides in nature Protein in nature
Part of Gram-negative bacterial cell wall Secreted both by Gram-positive and negative bacteria; diffuse into surrounding
medium
Part of Gram-negative bacterial cell wall Secreted both by Gram-positive and negative bacteria; diffuse into surrounding
medium
Released by cell lysis, Not by secretion Actively secreted by the bacteria
Released by cell lysis, Not by secretion Actively secreted by the bacteria
Highly stable Heat labile destroyed at 60 oC
Highly stable Heat labile destroyed at 60 oC
Mode of action – Induces ↑IL-1 and TNF Mostly enzyme like action
Mode of action – Induces ↑IL-1 and TNF Mostly enzyme like action
Only large doses are fatal More potent, even smaller doses fatal
Only large doses are fatal More potent, even smaller doses fatal
Poorly antigenic Highly an
Poorly antigenic Highly an
Neutralization by antibodies is ineffective Neutralized by specific antibodies
Neutralization by antibodies is ineffective Neutralized by specific antibodies
No effective vaccine is available using endotoxin Toxoid forms are used as vaccine, e.g. tetanus toxoid
No effective vaccine is available using endotoxin Toxoid forms are used as vaccine, e.g. tetanus toxoid